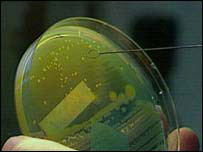
صورة

إباء
اضطرت وزارة الصحة في الكيان الصهيوني ، للكشف عن الجرثومة الفتاكة المتفشية في في الكيان الصهيوني، عقب فضح القناة الأولى من تلفزيون الكيان الصهيوني الأمر، والإفصاح عن عشرات حالات الوفاة في مستشفيات الكيان الصهيونيخلال الأشهر الأخيرة بسبب إصابتهم بالجرثومة القاتلة غير قابلة للعلاج بالمضادات الحيوية.
وأكد يعكوف بن يزري وزير الصحة في الكيان الصهيوني، أن وزارته على علم بتفشي جرثومة قاتلة " كلبسيانا " في المستشفيات الإسرائيلية منذ أيام، لكنها فضلت عدم إثارة الرعب بين المواطنين، بحسب تعبيره.
وقال يرزي خلال مقابلة مع راديو الجيش العدو الإسرائيلي أوردتها وكالة معا الفلسطينية، ان "هذه ليست المرة الأولى التي نواجه بها جرثومة فتاكة"، وأضاف في رسالة للتخفيف من غضب الجمهور الإسرائيلي، " نحن نواجه هذه المخاطر دائما، وليس فقط بالأيام الأخيرة وعندما تظهر مشكلة من هذا القبيل نحن مجبرون أن نفحصها لا ان نرعب المواطنين".
من جهته قال مدير عام وزارة الصحة البروفيسور افي يسرائيلي، ان ظاهرة تطوير الجراثيم للقدرة على مقاومة الأدوية غير جديدة وهي قائمة منذ سنوات في كل أنحاء العالم في الكيان الصهيوني أيضا، مبينا بان هذه الجرثومة موجودة في البلاد.
وبحسب المسؤول ، فان تطورها الجيني تم أيضا داخل الكيان الصهيوني ولا يعرف إن كان تم في الخارج أيضا محذرا في السياق ذاته، من ان هذه الجرثومة فتاكة أكثر من سابقاتها.
وذكرت معا الفلسطينية، بان القناة الأولى من تلفزيون الكيان الصهيوني، كانت قد كشفت النقاب عن العشرات من حالات الوفاة في مستشفيات الكيان الصهيوني خلال الأشهر الأخيرة بسبب إصابتهم بجرثومة قاتلة غير قابلة للعلاج بالمضادات الحيوية وانه تم رصد مئات حالات الإصابة بهذه الجرثومة التي تدعى" كلبسيانا" وان نسبة الوفيات التي تسببت تبلغ حتى الآن حوالي 30%.
جعلهم في هالحال وأردى
